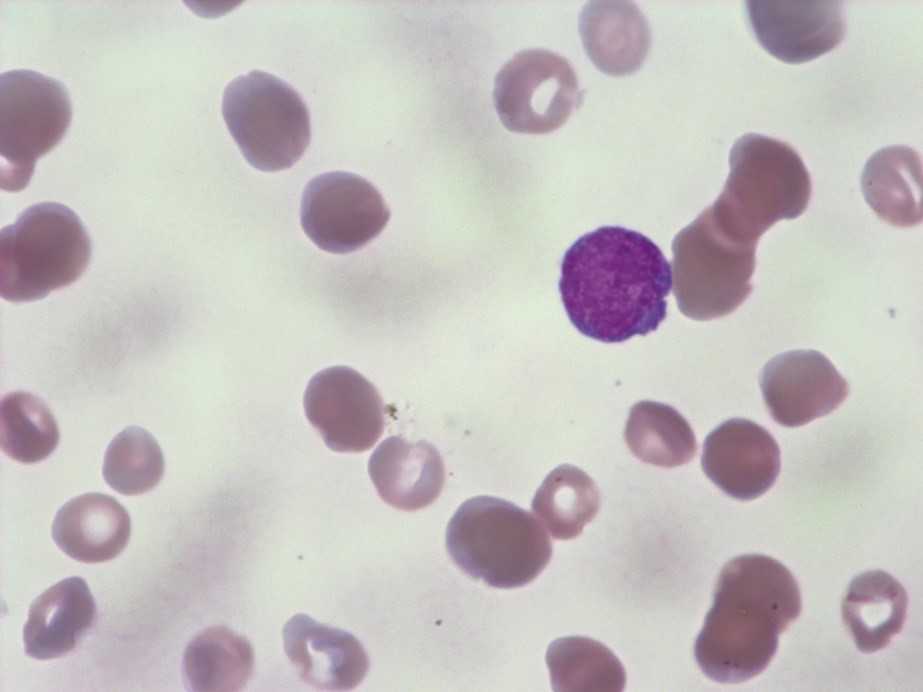

Профилактика заболевания
Для предотвращения заражения необходимо соблюдать следующие правила:
- Избегать общения кошки с уличными животными.
- Несколько раз в неделю мыть пол с хлорсодержащими веществами.
- Стирать подстилку питомца 1 раз в 3 месяца при высокой температуре.
- Предотвращать случайное спаривание домашнего любимца с другими животными.
- Не выпускать кошку на улицу.
- Давать питомцу витамины для поддержания нормальной работы иммунитета.
- Отказаться от низкокачественного корма.
- При первых симптомах лейкоза обратиться к ветеринару и не заниматься самолечением.

Подстилка для кошки всегда должна быть чистой
Группа риска
В группу риска заражения входят:
- пожилые животные;
- кошки после операции, которые часто бывают на улице;
- питомцы, подвергающиеся спариванию с непроверенными животными, которые могут быть носителями вируса;
- кошки, заражённые блохами и другими кровососущими насекомыми;
- животные, находящиеся в приюте.

Пожилые кошки чаще подвергаются заражению
Тестирование перед вакцинацией
Перед введением вакцины проводят тестирование кошки на наличие данного вируса. Такая процедура занимает не более 15 минут. Как проводится тестирование:
- Врач производит забор крови у кошки.
- Затем берёт отдельную тест-систему и помещает на неё 10 мкл крови животного. Такая манипуляция осуществляется с помощью автоматической пипетки.
- По истечении 15 минут ветеринар оценивает результат. Если тестирование подтвердило наличие вируса, то вакцинация не проводится.
Вакцинация
Чаще всего вакцинацию проводят с помощью препарата Пуревакс FelV, представляющего собой рекомбинатное вещество, состоящее из живых и мёртвых вирусных частиц. При этом при внедрении патогена в организм питомца иммунная система быстро распознает его и уничтожит, что обезопасит кошку от опасного для жизни недуга. Первую прививку желательно сделать животному в 8 недель от рождения, а вторую в 12, а уже потом повторять вакцинацию ежегодно.

Регулярная вакцинация кошки способна защитить от заражения лейкозом
Диагностика
Их многочисленных методов лабораторной диагностики, при подозрении на лейкоз применяют следующие:
Иммуноферментные реакции:
- Иммунодиффузии (РИД).
- Иммунофлуоресценции. (РИФ).
- Полимеризационная цепная. Идентифицирует возбудитель по его ДНК.
- Гематологические исследования. Микроскопия мазка крови выявляет высокий процент юных форм лейкоцитов.
- Гистологические исследования удалённой при операции опухоли.
Если исследования показали отрицательный результат, их дублируют спустя две недели. При повторном негативе диагноз «Лейкоз» исключают. Если тесты дали положительный ответ, назначают симптоматическое лечение и повторяют исследования через три месяца. Прогноз при повторном подтверждении результатов анализов неблагоприятный.

Виды заболевания
Лейкозом у кошек называется белокровие, в сосудах собирается много незрелых лейкоцитов. Возбудителем болезни является вирус (ретровирус), проникающий извне и пребывает внутри кошек постоянно. Как только иммунная система становится слабее, вирус активизируется, болезнь прогрессирует, после чего проникает в структуру ДНК, изменяя основные значения. Исходя из того, что патология поражает именно кровь, то вирусные клетки стремительно разносятся по всему организму кошек, а сам лейкоз быстро развивается.

shutterstock
Вирус может проникать в организм через внешнюю среду, в таком случае можно понять, что питомец где-то заразился. Вторым вариантом развития болезни является появление возбудителей во внутренних органах. Они формируются при неблагоприятных факторах, которые ветеринары и ученые не могут до конца определить.
Зачастую инфицирование кошек происходит из внешней среды, как правило, через кровь. Сам вирус имеет уникальную структуру, поскольку может совмещаться с другими патологиями, в результате чего выходит гибридная, опасная форма болезни.
Лейкоз крови у кошек очень опасен не только из-за стремительного прогрессирования. На практике есть случаи, когда маленькие коты после рождения не проживали с заболеванием более 2 лет. Лейкоз у кошек может передаваться, поэтому существует риск заражения окружающих животных. Заводчикам кошек можно не переживать за свое здоровье, ведь человек не способен заразиться, это означает, что инфицированные кошки будут безопасными для людей.

shutterstock
Протекание заболевания тяжелое, а основные провоцирующие факторы полностью не найдены. При диагностировании на ранних сроках болезни, результаты зачастую ошибочные и кошку спасти от гибели получается не всегда.
Хронический лимфобластный лейкоз
Лимфатическая лейкемия
Для лимфатической лейкемии характерны следующие симптомы:
- Потеря аппетита, резкое похудение. Слабость, головокружение, сильные головные боли. Усиление потоотделения.
- Увеличение лимфатических узлов (от размера с небольшую горошину до куриного яйца). Они не связаны с кожным покровом и легко перекатываются при пальпации. Их можно прощупать в области паха, на шее, подмышками, иногда в полости живота.
- При увеличении лимфатических узлов средостения, происходит сдавливание вены и возникает отек лица, шеи, рук. Возможно их посинение.
- Увеличенная селезенка выступает на 2-6 см из-под ребер. Примерно на столько же выходит за края ребер и увеличенная печень.
- Наблюдается частое сердцебиение и нарушение сна. Прогрессируя, хронический лимфобластный лейкоз вызывает у мужчин снижение половой функции, у женщин — аменорею.
Анализ крови при таком лейкозе показывает, что в лейкоцитарной формуле резко увеличено количество лимфоцитов. Оно составляет от 80 до 95 % . Количество лейкоцитов может достигать 400 000 в 1 мм³. Кровяные пластинки — в норме (или немного занижены). Количество гемоглобина и эритроцитов — значительно снижено. Хроническое течение болезни может быть растянуто на период от трех до шести-семи лет.
Лечение лимфолейкоза
Особенность хронического лейкоза любого вида в том, что он может протекать годами, сохраняя при этом стабильность. В этом случае, лечение лейкоза в стационаре можно и не проводить, просто периодически проверять состояние крови, при необходимости, заниматься укрепляющей терапией в домашних условиях. Главное соблюдать все предписания врача и правильно питаться. Регулярное диспансерное наблюдение — это возможность избежать тяжелого и небезопасного курса интенсивной терапии.

Фото: повышенное число лейкоцитов в крови (в данном случае – лимфоцитов) при лекозе
Если наблюдается резкий рост лейкоцитов в крови и состояние больного ухудшается, то возникает необходимость проведения химиотерапии с использованием препаратов Хлорамбуцил (Лейкеран), Циклофосфан и др. В лечебный курс включены также антитела-моноклоны Кэмпас и Ритуксимаб.
Единственный способ, который дает возможность полностью вылечить хронический лимфолейкоз — трансплантация костного мозга. Однако эта процедура является очень токсичной. Ее применяют в редких случаях, например, для людей в молодом возрасте, если в качестве донора выступают сестра или брат пациента. Необходимо отметить, что полное выздоровление дает исключительно аллогенная (от другого человека) пересадка костного мозга при лейкозе. Этот метод используется при устранении рецидивов, которые, как правило, протекают намного тяжелее и труднее поддаются лечению.
Ювенальный миеломоноцитарный лейкоз
Дети в возрасте от двух до четырех лет часто подвергаются особой форме хронической лейкемии, которая называется ювенальный миеломоноцитарный лейкоз. Он относится к наиболее редким видам белокровия. Чаще всего им заболевают мальчики. Причиной его возникновения считаются наследственные заболевания: синдром Нунан и нейрофиброматоз I типа.
На развитие заболевания указывают:
- Анемия (бледность кожных покровов, повышенная утомляемость);
- Тромбоцитопения, проявляющаяся носовыми и десневыми кровотечениями;
- Ребенок не набирает веса, отстает в росте.
В отличие от всех других видов лейкемии, эта разновидность возникает внезапно и требует незамедлительного медицинского вмешательства. Миеломоноцитарный ювенальный лейкоз практически не лечится обычными терапевтическими средствами. Единственный способ, дающий надежду на выздоровление, — это аллогенная пересадка костного мозга, которую желательно провести в максимально короткие сроки после диагностирования. Перед проведением этой процедуры ребенок проходит курс химиотерапии. В отдельных случаях возникает необходимость в спленэктомии.
Типы лейкозов
При развитии лейкоза происходит перерождение определенного вида кровяных клеток в злокачественные. На этом основывается классификация заболевания.
- При переходе в лейкозные клетки лимфоцитов (кровяных клеток лимфатических узлов, селезенки и печени) оно название носит название ЛИМФОЛЕЙКОЗ.
- Перерождение миелоцитов (кровяных клеток, образующихся в костном мозгу) приводит к МИЕЛОЛЕЙКОЗУ.
Перерождение других видов лейкоцитов, приводящее к лейкозу, хотя и встречается, но гораздо реже. Каждый из этих видов делится на подвиды, которых достаточно много. Разобраться в них под силу только специалисту, на вооружении которого имеется современная диагностическая техника и лаборатории, оснащенные всем необходимым.

Деление лейкозов на два основополагающих вида объясняется нарушениями при трансформации разных клеток – миелобластов и лимфобластов. В обоих случаях вместо здоровых лейкоцитов в крови появляются лейкозные клетки.
Помимо классификации по типу поражения, различают острый и хронический лейкоз. В отличие от всех других заболеваний, эти две формы белокровия не имеют ничего общего с характером протекания болезни. Их особенность в том, что хроническая форма практически никогда не переходит в острую и, наоборот, острая форма ни при каких обстоятельствах не может стать хронической. Лишь в единичных случаях, хронический лейкоз может быть осложнен острым течением.
Это обусловлено тем, что острый лейкоз возникает при трансформации незрелых клеток (бластов). При этом начинается их стремительное размножение и происходит усиленный рост. Этот процесс невозможно контролировать, поэтому вероятность смертельного исхода при этой форме заболевания достаточна высока.
Хронический лейкоз развивается, когда прогрессирует рост видоизмененных полностью созревших кровяных клеток или находящихся в стадии созревания. Он отличается длительностью протекания. Пациенту достаточно поддерживающей терапии, чтобы его состояние оставалось стабильным.
Описание вирусной лейкемии кошек
![]()
Ни одна кошка, какой бы ухоженной она ни была, не застрахована от вирусной лейкемии, поэтому каждому владельцу такого питомца рекомендуется знать, каким образом развивается это заболевание, ведь при неблагоприятном стечении обстоятельств оно может закончиться гибелью четвероногого любимца. Болезнь может протекать в разных формах, каждая из которых имеет определенные особенности.
Механизм развития болезни
Вирус данного заболевания распространен повсеместно. Его вспышки особенно часто регистрируются в регионах, где много бродячих животных.
Инфицирование происходит следующими путями:
- контактным – в ходе общения здорового животного с инфицированным котом или латентным вирусоносителем;
- аэрогенным – через слюну, выделения из глаз и носа;
- половым – при вязке с инфицированным партнером;
- бытовым – через корм или вещи зараженной особи;
- трансплацентарным – внутриутробно (через плаценту);
- трансмаммарным – инфекция передается котенку через молоко от инфицированной матери.
![]()
Факторы, способствующие проявлению болезни:
- стресс;
- слабый иммунитет;
- латентные инфекции;
- патологии вирусной, паразитарной и бактериальной этиологии;
- острые воспалительные процессы в организме.
![]()
Больше других заразиться вирусным лейкозом рискуют пожилые кошки, животные, содержащиеся в питомниках и гостиницах, а также с не сформированной или ослабленной иммунной системой. Попав в кошачий организм, вирус устремляется к органам, содержащим клетки с быстрым делением. Он поражает красный костный мозг, принуждая его синтезировать мутировавшие клетки крови с измененной структурой лейкоцитов и лимфоцитов. Именно с этим связано то, что вирусную лейкемию часто по ошибке принимают за рак крови, хотя этиологии этих патологий различны.
![]()
Проникший в организм питомца вирус может вызвать следующие последствия:
- Кот навсегда останется вирусоносителем, но инфекция у него не разовьется ввиду отсутствия благоприятных для размножения ретровируса условий. Как показывает статистика, внедрившийся FeLV инактивируется у 60% кошек.
- Ретровирус будет существовать в кошачьем организме в скрытой форме до тех пор, пока не активируется какой-либо патологией, сильным эмоциональным потрясением или приемом лекарственных препаратов, негативно действующих на иммунную систему.
- По завершении инкубационного периода животное заболеет вирусным лейкозом в осложненной форме.
Формы вирусной лейкемии
Когда FeLV распространяется в тканях организма, разносясь по лимфатическим путям и накапливаясь в лимфоузлах, патология еще обратима. Если он проникнет в костный мозг и начнется его разрушение, организму кошки уже не удастся побороть инфекцию, шанс излечиться практически равен нулю. Патологический процесс может протекать в разных формах, которые зависят от состояния иммунитета животного:
![]()
- Транзиторная, или временная. Характерна для начальных стадий болезни, пока ретровирус не достиг костного мозга. Крепкая иммунная система отражает атаку патогенных агентов, вследствие чего инфекция не развивается. Этот вариант развития заболевания диагностируется не так часто.
- Латентная. Форма скрытого носительства также возможна при наличии крепкого иммунитета. FeLV находится в тканях, однако условия для его активизации и распространения по организму отсутствуют. Животное может быть латентным вирусоносителем в течение длительного времени. Оно не болеет, но является источником инфекции для других.
- Персистентная. Вирус размножается из-за того, что ослабленная иммунная система не способна отражать атаку FeLV на костный мозг. Вирус разносится по организму лейкоцитами, его концентрация в кровотоке высока, поэтому проявления болезни со временем нарастают.
- Нетипичная. Представляет собой частично эффективный ответ иммунной системы, при котором ретровирус развивается в каком-либо отдельном органе.
Что такое костный мозг, кровь и лимфоидная ткань?
Различные типы лейкемии начинаются в определенных типах клеток крови. Для того, чтобы понять принцип развития заболевания и его влияния на организм, нужно разобраться с работой основных тканей тела.
Костный мозг
Эта мягкая внутренняя часть некоторых костей – черепа, лопаток, ребер, таза и позвоночника состоит из:
- Жировых клеток.
- Небольшого количества стволовых клеток, из которых образуются различные клетки крови.
- Зрелых кроветворных клеток.
- Поддерживающих тканей, которые помогают клеткам расти.
Внутри костного мозга стволовые клетки делятся, созревают и образуют новые клетки крови, которые становятся лейкоцитами, эритроцитами, лимфоцитами или тромбоцитами.

Типы клеток крови Красные кровяные тельца, или эритроциты, переносят кислород из легких в другие ткани и возвращают углекислый газ обратно в дыхательные пути. Их нехватка – анемия, может вызвать слабость, усталость и одышку – нехватку воздуха.
Тромбоциты необходимы для закупорки вызванных порезами или ушибами отверстий в кровеносных сосудах. Если в теле человека их слишком мало, у него развиваются кровотечения и появляются кровоподтеки.
Белые кровяные тельца, или лейкоциты, помогают организму бороться с инфекциями. При понижении их уровня работа иммунной системы нарушается, а вероятность заражения – увеличивается.
Типы лейкоцитов Лимфоциты – это полностью зрелые противостоящие инфекциям клетки, которые развиваются из лимфобластов – особого типа стволовых клеток костного мозга. Именно из них в основном состоит лимфоидная ткань иммунной системы, находящаяся в лимфатических узлахЛимфатические узлы – это небольшие органы иммунной системы, задерживающие и обезвреживающие опасные для организма вещества., вилочковой железеВилочковая железа, или тимус – небольшой орган, расположенных за верхней частью грудины, перед сердцем. В нем происходит созревание и развитие некоторых лимфоцитов., селезенкеСелезенка производит лимфоциты, уничтожает микроорганизмы и другие вредные вещества, а также хранит нормальные клетки крови., миндалинахМиндалины – расположенные в задней части глотки скопления лимфатической ткани, которые участвуют в выработке антител – белков, не позволяющих вдыхаемым и проглатываемым микроорганизмам размножаться., а также дыхательной и пищеварительной системах.
- В-лимфоциты: защищают организм от микробов. Именно они чаще всего становятся лейкозными. Созревают и превращаются в плазматические клетки, вырабатывающие антитела – белки, которые прикрепляются к микробам – бактериям, вирусам и грибкам, благодаря чему их распознают и уничтожают гранулоциты.
- Т-лимфоциты: распознают зараженные вирусами клетки, разрушают их и регулируют активность иммунной системы.
Гранулоциты: борются с инфекциями. Развиваются из особых клеток костного мозга – миелобластов, содержат в себе ферменты – белки и другие вещества, способные уничтожать бактерии.
Моноциты. Развиваются из присутствующих в костном мозге монобластов. На протяжении примерно суток они циркулируют в кровотоке, после чего проникают в различные ткани и превращаются в макрофаги, способные переваривать некоторые виды микробов. Кроме того, они помогают лимфоцитам распознавать опасные микроорганизмы и вырабатывать антитела для борьбы с ними.
Все эти клетки содержатся в теле человека в определенном количестве. Нарушение правильного баланса и замещение их на измененные клетки приводит к тяжелым последствиям – сбоям в работе всех систем, включая дыхательную, иммунную, кровеносную и пищеварительную, и отказу важнейших органов.
Вирусная лейкемия кошек
Вирусная лейкемия кошек (лимфосаркома, лейкемия, лейкоз) — это заболевание, поражающее гемолимфопоэтическую систему кошек.
Возбудитель лейкемии кошек — РНК-содержащий вирус семейства Retroviridae, подсемейства Oncornavirinae, рода онковирусов, типа С, вида онковируса кошек (FeLV).
Вирус может быть проявлен в 2 формах — эндогенной (непатогенной) и экзогенной (патогенной).
Возбудитель вирусного лейкоза кошек опасен для особей всех пород, включая диких. Заражение происходит при контакте через слизистые оболочки респираторных путей и органов ЖКТ, кровь, плаценту инфицированной матери, а также во время грудного кормления.
В некоторых случаях данный вирус не проявляет себя годами, в то время как другие вирусы могут стремительно атаковать организм животного.
Лимфоидный лейкоз у кошек имеет 4 формы проявления:
- вилочковая,
- полицентрическая,
- алиментарная
- подлинная лейкемия.
Наиболее распространены тимусная лимфосаркома и лимфатическая лейкемия. Кроме того, вирус вызывает ретикулосаркому и гранулоэритромонозную лейкемию.
Существует три вида штаммов вируса лейкемии кошек:
- FeLV-A — угроза иммунной системы
- FeLV-В — развитие опухолей
- FeLV-С — вызывает анемию
Эти штаммы представляют собой разновидность ретровируса, и животное может иметь один или комбинацию нескольких штаммов. Дифференцировать штаммы, к сожалению, невозможно на ранних стадиях.
Симптомы вирусного лейкоза кошек различны и зависят от штамма. Визуально можно отметить:
- Анемичные или иктеричные слизистые оболочки
- Лимфаденопатию
- Хроническое течение респираторных инфекций
- Необъяснимая потеря аппетита, веса (даже при сохраненном аппетите)
- Ухудшение качества шерсти
- Слабость, вялость
- Периодическая гипертермия
- Желудочно-кишечные расстройства
- Стоматит
Диагностика
Для диагностики вируса лейкоза кошек проводится два типа тестов крови: иммуноферментный анализ (ИФА) и иммунофлуоресценция (МФА). Также проводится ПЦР диагностика. Желательно использовать сразу все возможные варианты диагностики, так как возможен вариант ложноотрицательного результата.
Если котенок дал положительный результат на вирус лейкоза кошек в возрасте до 16 недель, рекомендуется пройти повторное тестирование после того, как ему исполнится более 16 недель, поскольку результат может оказаться положительным из-за колострального иммунитета.
Вирус лейкемии кошек является вредоносным. Как только поставлен диагноз этого заболевания, кошка заразна и является носителем вируса.
Наблюдаются следующие макроскопические симптомы при злокачественной форме:
- кахексия
- анемия
- увеличение селезенки
- незначительное увеличение лимфатических узлов немного увеличены
- костный мозг однородно окрашен в светло-красный цвет с серым оттенком.
Возможны признаки вторичных осложняющих болезней: плеврит, пневмонию и другие.
Более 80% кошек, инфицированных вирусом лейкоза, умирают в течение трех лет после постановки диагноза. Однако регулярные ветеринарные осмотры и профилактические мероприятия могут помочь «cдержать» развитие патологии на некоторое время и помочь защитить их от вторичной инфекции. Все инфицированные питомцы должны быть кастрированы и помещены в отдельное пространство.
В настоящее время специфического лечения лейкоза кошек нет. В случае появления других заболеваний в назначении их лечения всегда необходимо учитывать вирус лейкоза в организме, так как некоторые действия, как и сами эти заболевания, могут спровоцировать его агрессивное течение.
В случае возникновения онкологического проявления лейкоза (лимфомы) необходимо проводить химиотерапию. Данный диагноз ставится на основе цитологического или гистологического материала (пораженные органы, лимфатические узлы, костный мозг).
Не допускать скученного содержания животных в одном помещении. Вновь приобретенных кошек следует помещать в карантин, проводить исследования на возможные скрытые инфекции.
В случае, если питомец находится на свободном выгуле, можно рассмотреть вариант вакцинации. Но вакцинации подвергаются только те животные, которые проверены на отсутствие лейкоза методом ИФА и ПЦР минимум 2-3 раза с интервалом 3-4 недели. Вакцинация не дает 100% гарантии, поэтому лучше избегать контакта с потенциальными носителями.
Симптомы и признаки заражения у кошки
Кошка на приеме у ветеринараТеперь нужно разобраться как протекает ВИЧ у кошек, его симптомы в зависимости от стадии заболевания будут отличаться. Так, после заражения могут наблюдаться не только повышение температуры, но и снижение аппетита, истощение, в то время как анализ крови будет показывать лейкопению, то есть уменьшение уровня лейкоцитов в крови.

На второй стадии заболевания лихорадка уже бывает редко. Основные симптомы связаны с присоединившимися вторичными инфекциями, например, у большинства животных, страдающих этим заболеванием, наблюдаются хронический стоматит и некоторые патологии носоглотки. У самок часто диагностируют токсоплазмоз. Развиваются кожные заболевания, связанные с бактериальной или грибковой инфекций, иногда — с паразитарным заражением.
Хронические риниты с постоянными выделениями из носа, регулярные поносы — все это тоже может быть симптомами ВИК-инфекции. Интересно! Клиническая практика показывает, что примерно в 18% случаев аналог ВИЧ у кошек протекает бессимптомно, а затем начинает прогрессировать, но медленно. И примерно в таком же количестве случаев регистрируется интенсивное течение болезни.
Прямая ВИК-инфекция может вызывать неврологические заболевания, в том числе проявляющиеся поведенческими нарушениями и плохой двигательной координацией.
Что провоцирует / Причины Лейкоза у детей:
Сегодня доказанной является роль онкогенных вирусных штаммов, радиационного излучения, наследственной предрасположенности, химических факторов, эндогенных нарушений на возникновение лейкоза у детей. Лейкоз вторичный может появиться в результате лучевой или химиотерапии, которые были проведены для лечения другого заболевания (окнологического).
У детей с диагнозом «болезнь Дауна» лейкоз бывает примерно в 15 раз чаще, чем у детей без такой болезни. Также в группе риска дети с такими заболеваниями:
- синдром Клайнфельтера
- синдром Ли-Фраумени
- синдром Блума
- синдром Вискотт-Олдрича
- первичные иммунодефициты
- анемия Фанкони
- полицитемия и т.д.
Факторы риска при лейкозах у детей
Факторами риска считаются любые влияния, которые увеличивают вероятность заболевания ребенка лейкозом. Сюда относят вредные привычки, нездоровое питание, многочасовое пребывание на солнце. Важную роль играют генетические факторы риска, которые были перечислены выше.
Если у одного из сиблингов в возрасте до 6 лет возник острый лейкоз, то вероятность 20-25%, что лейкоз обнаружат со временем и у второго сиблинга.
Больные, которые получают интенсивную терапию с целью угнетения иммунных функций, имеют повышенный риск развития опухолей, особенно лимфоидной системы, в том числе острого лимфобластного лейкоза.
Диагностика
Кровь больного животного может быть исследована методом ПЦР.
Чтобы подтвердить лейкоцитоз у кошек, берут анализ крови, который покажет наличие в организме чужеродного патогена. Зачастую проводятся такие лабораторные исследования:
- Полимерная цепная реакция. Это высокоточный экспресс-тест, показывающий наличие вируса в клетках костного мозга.
- Иммуноферментный анализ. Показывает наличие в крови продуктов жизнедеятельности патогена.
- Общий анализ крови. Помогает определить нарушение состава плазмы и наличие в организме воспалительных процессов.
Для подтверждения диагноза ветеринар дополнительное даст направление на такие инструментальные методы исследования, как:
- рентгенография;
- УЗИ;
- МРТ или КТ.
Лечение лейкоза у кошек
Способ лечения подбирается только после качественной дифференциальной диагностики
Важно выявить, какие органы уже поражены злокачественными новообразованиями. К сожалению, вылечить заболевание полностью не представляется возможным, однако с помощью современных медикаментов можно продлить жизнь питомцу
Знакомая взяла котёнка из приюта, который постоянно болел. Не успевали лечить один недуг, как появлялся другой. В итоге кошку повезли на полное обследование. Анализ крови показал наличие лейкоза, что очень расстроило мою знакомую. Кошечку всё время рвало, она не вставала и не могла сходить в туалет. Ветеринар посоветовал комплексное лечение, включающее в себя противовирусные и другие препараты. Врач рекомендовал также сделать повторный анализ крови, который не подтвердил наличие лейкоза. Что послужило причиной подобного состояния животного, так и не понятно. Как оказалось, первый результат анализа был ложноположительным, поэтому сдавать кровь рекомендуется 2 раза. Что спасло кошку, так до сих пор и не ясно. Однако нужно помнить, что лучше перестраховаться и сдать анализ крови дважды, чем потом жалеть об упущенном времени.
Методы диагностики
Определить вирусную инфекцию можно с помощью ПЦР диагностики и иммуноферментного анализа крови. Также существует специальный тестер, позволяющий выявить лейкоз в домашних условиях. Такой метод не даёт 100% достоверного результата, однако помогает заподозрить присутствие патогена в организме. Данный способ определяет наличие характерных антител в крови животного. Процедуру проводит ветеринар, который приносит с собой специальный тестер. После забора крови врач должен выждать 15 минут. Две окрашенные полосы свидетельствуют о положительном результате, одна — об отрицательном.

Экспресс-тест для определения лейкоза у кошек позволяет выявить вирус в домашних условиях
Полимеразная цепная реакция (ПЦР) в данном случае является более эффективной. Она позволяет выявить ДНК вируса в крови питомца и поставить точный диагноз. Иммуноферментный анализ (ИФА) основан на определении антител, которые формируются при внедрении чужеродных агентов. При этом также можно выявить стадию патологического процесса.
Общий анализ крови применяют для определения состояния организма в целом. При лейкозе изменяется количество лейкоцитов, повышается скорость оседания эритроцитов и снижается гемоглобин.

Анализ крови является главным способом диагностики при подозрении на лейкоз
Вспомогательным методом исследования является УЗИ. Ультразвуковая диагностика позволяет определить увеличенные лимфоузлы, а также опухоли. Такой способ помогает врачу выявить поражённые области и даёт возможность подобрать необходимый способ лечения. Дополнительно также может применяться МРТ. Магнитно-резонансная томография даёт возможно определить даже небольшие опухоли.

УЗИ позволяет выявить опухоли у кошек
Терапевтическая тактика
На начальных стадиях развития заболевания применяют иммуностимулирующие средства, которые являются бесполезными в запущенных случаях. При этом назначают Интерферон, который активизирует защитные силы организма на борьбу с вирусом, в результате чего можно продлит жизнь питомцу. Однако такой медикамент эффективен не в каждом случае.

Интерферон может применяться на начальных стадиях заболевания
Ввиду того что вирус лейкоза схож по свойствам с ВИЧ, нередко назначают препарат Азидотимидин, который применяют для поддерживающей терапии людей с иммунодефицитом. Этот медикамент подавляет размножение патогена, улучшая общее самочувствие. Лекарство применяют для терапии не только ВИЧ-инфицированных людей, но и используют при борьбе с лейкозом у кошек. Схожим по действию является препарат Ралтегравир, который позволяет продлить жизнь больного питомца.
При присоединении вторичной инфекции назначают антибиотики. Для быстрого устранения бактериального очага применяют Амоксиклав, Ципровет, Синулокс и др. Указанные препараты следует давать больному животному курсом не более 7–10 дней.

Амоксиклав способствует устранению очага инфекции
При непроходимости кишечника, которая часто возникает при поражении злокачественным процессом органов ЖКТ, прибегают к хирургическому вмешательству. Операцию нередко сочетают с химиотерапией, позволяющей снизить прогресс роста опухоли. В сочетании с указанными методами важную роль играет диета, дающая возможность улучшить состояние питомца. При этом исключается вся пища, не прошедшая термическую обработку. Корм перетирается до пюреобразного состояния и даётся питомцу 3–4 раза в день.
Лейкоз кошек: симптомы
Вирусная лейкемия коварна тем, что ее признаки проявляются далеко не сразу после заражения. Инкубационный период занимает до 4 месяцев. Заболевание может перейти в латентную форму, и не проявлять себя. В обоих случаях поведение и внешний вид кошки никак не меняется, возможно легкое недомогание, которое незаметно для владельца.
Первые симптомы вирусной лейкемии у кошек не специфичны, похожи на другие заболевания.
- Кошка становится вялой, сонливой, теряет интерес к играм, у нее повышается температура и обильно выделяется слюна. Хозяева обычно принимают такое состояние за простуду. Иногда наступает облегчение, и животное чувствует себя лучше. Периоды ухудшений и улучшений состояния чередуются до года, иногда больше.
- Параллельно с общим ухудшением состояния возникают сопутствующие заболевания. Несмотря на то, что вирус лейкоза кошек повышает количество лейкоцитов в крови, иммунитет животного он угнетает. Питомец простывает и болеет циститом чаще обычного, возникает понос и рвота, непереносимость некоторых видов пищи. Котик отказывается от любимого корма, шерсть теряет блеск, выпадает.
- При внимательном осмотре заметна бледность слизистых. Смотреть нужно на слизистую пасти и внутреннюю сторону век. Если они устойчиво и равномерно побледнели – это один их достоверных признаков ВЛК. Мочка носа и подушечки лап содержат пигменты, поэтому их цвет может не измениться.
- При грудной форме лейкоза главный симптом – одышка. Сначала она появляется при физической активности, затем в покое. Одышка у кошек проявляется учащенным поверхностным дыханием, иногда с вываленным языком. Главная опасность грудного лейкоза – накопление жидкости в плевральной полости, оно и приводит к одышке. Реже возникает перикардит со скоплением жидкости в сердечной сумке. Он так же проявляется одышкой, кошка становится вялой, перестает бегать и запрыгивать на высокие поверхности.
- Проявления брюшной формы разнообразны. Чаще всего это различные нарушения пищеварения – поносы, запоры, примеси крови и слизи в кале, рвота, отказ от пищи. Самые грозные осложнения – обезвоживание и кишечное кровотечение. Они приводят к быстрой гибели питомца.
- Другой опасный вариант брюшной формы – гломерулонефрит. Это поражение мозгового вещества почек. Нарушается способность этого органа фильтровать кровь и образовывать мочу. Цвет мочи становится красным, ее объем увеличивается. Поражение почек по типу пиелонефрита возникает на фоне частых циститов. Кошка часто ходит в туалет, выделяет мочу небольшими порциями, иногда «не доносит» до лотка.
Многоочаговая форма – это сочетание всех вышеописанных поражений. Прогноз неблагоприятный – срок жизни больного питомца не более 10 лет. Кошка умирает от осложнений лейкоза – истощения, анемии, кровотечения и сепсиса. Время наибольшего риска – 3-4 года после заражения, в этот период гибнет большинство питомцев.






























